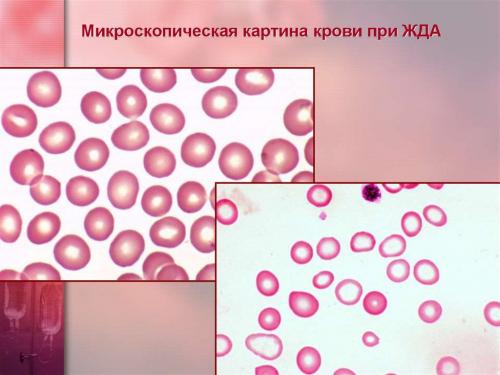
Какие причины могут привести к дефициту железа в организме. Что такое ЖДА

Основные функции печени, почек и железа: как поддерживать их здоровье
- Основные функции печени, почек и железа: как поддерживать их здоровье
 - Связанные вопросы и ответы
 - Какие функции выполняет печень в организме
 - Какие проблемы могут возникнуть при нарушении функций почек
 - Как важно для организма поддерживать нормальный уровень железа
 - Что такое гемотест и какие данные он позволяет получить о состоянии организма
 - Какие причины могут привести к дефициту железа в организме
 - Какие анализы необходимо сдать для оценки работы печени
 - Какие факторы могут повлиять на функциональное состояние почек
 - Какими путями железо поступает в организм человека
 - Какие симптомы могут указывать на проблемы с печенью
 
Основные функции печени, почек и железа: как поддерживать их здоровье
Роль печени в нашем организме трудно переоценить. Ведь самая крупная железа пищеварительной системы, которую нередко называют «вторым сердцем человека», выполняет десятки разнообразных функций, среди которых:
- Пищеварительная функция. Печень является неотъемлемой частью пищеварительной системы. Именно в этом жизненно важном органе человека происходит выработка желчи, которая через сфинктер Одди поступает в двенадцатиперстную кишку и выводится из организма. За сутки человеческая печень способна выделять до 1,5 л желчи, которая, в свою очередь, принимает активное участие в процессах пищеварения.
 - Барьерная (защитная) функция. Это одна из самых важных задач печени. Будучи своеобразным фильтром в человеческом организме, она принимает активное участие в деактивации и обезвреживании токсических веществ, которые поступают извне. Кроме того, именно в клетках этого органа происходит переработка ядовитых веществ (фенола, индола и т.д.), которые образуются как результат работы микрофлоры кишечника.
 - Метаболическая функция. Печень принимает активное участие в обмене белков, жиров, углеводов и витаминов. Она способна вырабатывать резервный белок, превращать гликоген в глюкозу, расщеплять ряд гормонов, а также синтезировать витамины А и В12.
 - Функция кроветворения. Печень – это «депо крови». Именно она является основным источником обогащения и главным резервуаром крови, именно в ней производятся вещества, которые необходимы для нормального свертывания крови.
 
Связанные вопросы и ответы:
1. Какие функции выполняет печень в организме
Ответ: Печень выполняет множество функций, включая очистку крови от токсинов, участвует в обмене веществ, выработке желчи для пищеварения, хранении витаминов и минералов, участвует в образовании белков и ферментов, а также накапливает запасы энергии в виде гликогена.
2. Какие заболевания могут возникнуть у печени
Ответ: У печени могут возникнуть различные заболевания, такие как цирроз, гепатит, жировая дистрофия, печеночная недостаточность, опухоли. Они могут быть вызваны вирусами, алкоголем, неправильным питанием, лекарствами или генетическими предрасположенностями.
3. Какую роль играют почки в организме
Ответ: Почки играют важную роль в организме, участвуя в процессе очистки крови от шлаковых веществ, регулируя водно-электролитный баланс, уровень кровяного давления, продуцируя гормоны, контролируя кислотно-щелочной баланс и участвуя в образовании красных кровяных клеток.
4. Какие заболевания могут появиться у почек
Ответ: К почечным заболеваниям относятся гломерулонефрит, пиелонефрит, почечная недостаточность, камни в почках, поликистоз почек. Они могут возникнуть из-за инфекций, нарушения обмена веществ, гипертонии, а также генетических факторов.
5. Зачем проводят гемотест на железо
Ответ: Гемотест на железо проводят для определения уровня железа в крови. Низкий уровень железа может говорить о наличии анемии, а высокий уровень может свидетельствовать о гемохроматозе или других заболеваниях. Точное значение железа помогает диагностировать и лечить соответствующие заболевания.
Какие функции выполняет печень в организме
| Печень | |
|---|---|
|  лат.   jecur, iecur др.-греч. ἧπαρ (hepar)  | |
   Печень человека расположена в верхней правой части брюшной полости  | |
|   Положение печени (отмечена красным) в теле мужчины  | |
| Система | пищеварительная | 
| Кровоснабжение |  собственная печёночная артерия  | 
| Венозный отток |  печёночные вены  | 
| Иннервация |  чревные ганлии  | 
| Лимфа |  гепатические лимфоузлы  | 
| Прекурсор |  передняя кишка  | 
| Каталоги | |
|    Медиафайлы на Викискладе  |  | 
Пе́чень ( лат. jecur, iecur , др.-греч. ἧπαρ ) — жизненно важная железа внешней секреции позвоночных животных, в том числе и человека , находящаяся в брюшной полости (полости живота ) под диафрагмой и выполняющая большое количество различных физиологических функций. Печень является самой крупной железой позвоночных.
Печень (лат. jecur, iecur, др.-греч. ἧπαρ) — жизненно важная железа внешней секреции позвоночных животных, в том числе и человека, находящаяся в брюшной полости (полости живота) под диафрагмой и выполняющая большое количество различных физиологических функций.
Основные функции печени:
- Фильтрация крови: печень очищает кровь от токсинов, вредных веществ и других чужих веществ, что обеспечивает здоровье организма.
 - Производство желчи: печень производит желчь, которая помогает переваривать жирную пищу и извлекать из неё питательные вещества.
 - Метаболизм: печень играет важную роль в обмене веществ, синтезе гормонов и других биологически активных веществ.
 - Утилизация витаминов: печень утилизирует витамин К, витамин Д и другие витамины, необходимые для здоровья.
 - Обмен белка: печень помогает обмену белка, что обеспечивает здоровье кожи, волос, ногтей и других тканей.
 - Протезирование: печень играет важную роль в защите организма от инфекций и воспалений.
 
Печень является самой крупной железой позвоночных, и ее функции не только жизненно важны, но и обеспечивают здоровье и благополучие организма.
Печень изучает медицинская наука гепатология , врачебная специальность специалиста по заболеваниям печени — гепатолог, чаще всего это гастроэнтеролог , специализирующийся на патологиях печени. В российском списке врачебных специальностей нет специальности «гепатолог».

Печень состоит из двух долей: правой и левой. В правой доле выделяют ещё две вторичные доли: квадратную и хвостатую. По современной сегментарной схеме, предложенной(1957), печень разделяется на восемь, образующих правую и левую доли. Сегмент печени представляет собой пирамидальный участок печёночной паренхимы, обладающий достаточно обособленным,и оттоком. Хвостатая и квадратная доли, располагающиеся сзади и спереди от ворот печени, по этой схеме соответствуют SIи SIVлевой доли. Помимо этого, в левой доле выделяют SIIи SIIIпечени, правая доля делится на SV — SVIII, пронумерованные вокруг ворот печени по ходу часовой стрелки.
Какие проблемы могут возникнуть при нарушении функций почек
Причиной острой дисфункции почек могут выступать различные ренальные и экстраренальные повреждающие факторы:- Нарушение перфузии почек: при сниженном объеме циркулирующей крови (при шоковых состояниях, обширных ожогах, кровотечениях, повышенном выведении жидкости из организма); при сниженном системном давлении, малом сердечном выбросе.
 - Повреждение структур почек: сосудов (при коагулопатиях, васкулитах, жировой эмболии); клубочкового аппарата (при гломерулонефрите, миеломной болезни, аутоиммунных заболеваниях); тубулярной системы (при приеме лекарственных препаратов, при воспалительных, онкологических заболеваниях).
 - Нарушение оттока мочи: при мочекаменной болезни; при гиперплазии предстательной железы; при рубцовых изменениях и опухолях мочевыделительных каналов.
 - Отсутствие почек.
 
- люди старше 65 лет, лица негроидной расы;
 - прием некоторых препаратов;
 - малый объем употребляемой жидкости;
 - сниженное артериальное давление;
 - сопутствующие заболевания, включая анемию, сахарный диабет, гипертоническую болезнь, атеросклероз почечных артерий, сердечную недостаточность.
 
- хронические заболевания почек ( гломерулонефрит , пиелонефрит );
 - аутоиммунное поражение (амилоидоз, склеродермия, системная красная волчанка);
 - сахарный диабет , гипертоническая болезнь, подагра ;
 - атеросклеротическое поражение почечных сосудов.
 
Как важно для организма поддерживать нормальный уровень железа
Железо помогает поддерживать многие важные функции организма, влияя на уровень жизненной энергии, концентрацию внимания, желудочно-кишечные процессы, иммунную систему и регуляцию температуры тела. Его недостаток или избыток моментально сказывается на самочувствии.
Обменные процессы
Железо — важный компонент гемоглобина, состоящего из красных кровяных телец (эритроцитов). Гемоглобин содержит около двух третей железа в организме. Он соединяется с кислородом, а эритроциты разносят его из легких по всему телу. Этот минерал также входит во многие элементы, отвечающие за холестериновый обмен, переработку калорий в энергию, борьбу с токсинами. Благодаря железу со своими функциями лучше справляется иммунная система, а эритроциты с его помощью отправляют углекислый газ в легкие для переработки. Оно также необходимо для поддержания здоровья клеток, кожи, волос и ногтей.
Беременность
В период беременности в женском организме увеличивается количество жидкости. За счет этого резко растет объем крови и производство эритроцитов, которые нужны для обеспечения плода кислородом и необходимыми веществами. Кровь становится жиже, падает уровень гемоглобина. Организм потребляет железо максимально. Дефицит минерала может привести к ранним родам, низкому весу младенца после рождения, а также к нарушению его когнитивного развития. Беременные женщины с железодефицитом больше склонны к инфекционным заболеваниям, поскольку он негативно влияет на иммунную систему .
Энергия
Недостаточное количество железа в рационе может повлиять на эффективность, с которой организм использует энергию. Благодаря роли переносчика кислорода к мышцам и мозгу, железо играет важную роль в умственной и физической активности. Низкий уровень этого элемента может привести к проблемам с концентрацией внимания, раздражительности и снижению выносливости.
Что такое гемотест и какие данные он позволяет получить о состоянии организма

С 1 октября в любом отделении Лаборатории «Гемотест» в рамках проекта «Страна Гемотест» проводятся три комплексных исследования стоимостью по 190 рублей каждое*: «Печень, почки и железо», « Сердце и сосуды » и «Щитовидка и глюкоза.
Медицинские эксперты Лаборатории «Гемотест» разработали комплексы анализов, позволяющие оценить общее состояние всех систем организма и выявить возможные бессимптомные нарушения. При обнаружении отклонений пациенты получают бесплатную очную или телемедицинскую консультацию врача.
 Также все участники проекта «Страна Гемотест» в течение 30 дней с момента оплаты анализа могут воспользоваться 20% скидкой на диагностические услуги: электрокардиограмму и ультразвуковую диагностику.
 « Страна Гемотест » — это комплексный проект, направленный на скрининг и раннее выявление заболеваний, а также бесплатное медицинское сопровождение. При наличии показаний пациента направляют в профильные лечебные учреждения для углубленной диагностики и полноценного лечения. Предоставление консультативной поддержки оказывается также посредством сотрудничества с пациентскими организациями. С 1 октября проект « Страна Гемотест » начал работу в отделениях «Гемотест» на всей территории Российской Федерации», - сообщила руководитель департамента медицинского маркетинга Лаборатории «Гемотест» Татьяна Иванова.
 Скрининг «Печень, почки и железо» включает в себя анализы на АЛТ, АСТ, креатинин и сывороточное железо , которые позволяют оценить общее состояние организма и выявить возможные предвестники серьёзных хронических заболеваний.
 Комплекс «Сердце и сосуды» определяет показатели общего холестерина, триглицеридов , а также МНО с протромбиновым временем и протромбиновым индексом, благодаря которым можно проверить здоровье сердечно-сосудистой системы, обнаружить возможные скрытые нарушения в работе сердца и оценить риск атеросклероза, инфаркта и инсульта.
 Исследование «Щитовидка и глюкоза» состоит из анализов на уровень глюкозы и тиреотропный гормон , отвечающих за здоровье щитовидной железы и риск развития сахарного диабета.
Многие заболевания длительно протекают бессимптомно. Своевременная диагностика позволяет быстро и эффективно пройти необходимое лечение, избежать осложнений и жить здоровой, полноценной жизнью. Позаботьтесь о себе и своих близких вместе с «Гемотест», станьте частью « Страны Гемотест ».
Организатор вправе менять условия и сроки проведения акции.
* взятие биоматериала оплачивается отдельно.
Какие причины могут привести к дефициту железа в организме
ЖДА называют состояние, при котором в организме наблюдается дефицит железа, что провоцирует уменьшение количества эритроцитов. В результате развиваются различные нарушения в работе организма, в первую очередь связанные с неполноценным протеканием газообмена. Поэтому для железодефицитной анемии характерна слабость, головокружения и даже потеря сознания, а также ряд других изменений в состоянии. Подобное может быть следствием как недостаточного поступления железа с пищей, так и нарушением его усвоения в организме или чрезмерного расходования.
Поэтому железодефицитная анемия не может быть первичным заболеванием. Она всегда является следствием возникновения тех или иных нарушений. При этом на нее приходится порядка 80% всех анемий, что требует внимательного отношения к этой проблеме и ее детального рассмотрения.
Статистика ВОЗ показывает, что более 2 млрд. людей во всем мире страдают от железодефицитной анемии. Но это только по официальным данным. В действительности их количество существенно выше.

В норме железо поступает в организм вместе с растительной и животной пищей. В растительных источниках оно содержится в форме трехвалентного железа, а в животных – двухвалентного. Эти формы железа отличаются разной скоростью и степенью всасывания. Железо из животных источников пищи или гемовое всасывается легко. А вот полученное из растительной еды трехвалентное или негемовое железо должно сначала трансформироваться под действием соляной кислоты желудка в двухвалентное, а после поступления с пищевым комком в начальные отделы тонкого кишечника снова перейти в трехвалентную форму.
Часть железа накапливается в слизистой оболочке тонкого кишечника, а остальное всасывается в кровь. Причем в сутки может всосаться не более 2,5 мг железа. В крови его связывает белок трансферрин, за продукцию которого отвечает печень. Количество всасываемого и депонированного в кишечнике железа регулируется в зависимости от его уровня в организме. Если с пищей поступает избыток железа, оно в большем объеме задерживается в клетках слизистой оболочки тонкого кишечника, которые впоследствии естественным образом слущиваются и выводятся вместе с каловыми массами.
Всосавшееся в кровоток железо переносится трансферрином по двум основным направлениям:
- через воротную вену оно попадает в печень, где откладывается в виде белка ферритина;
 - доставляется до клеток красного костного мозга, где задействуется для синтеза гемоглобина и принимает участие в тканевых окислительно-восстановительных реакциях.
 

Если на любом из этих этапов возникают нарушения, в организме развивается недостаток железа. Так, при снижении кислотности желудочного сока, что может быть следствием атрофического гастрита, использования антацидов, резекции желудка, способность организма превращать двухвалентное железо в трехвалентное снижается. Это значит, что оно не может полноценно всасываться и в дальнейшем участвовать в биохимических превращениях.
При развитии хронических патологий, затрагивающих слизистые оболочки кишечника, их способность всасывать железо также уменьшается. Поэтому оно не может в достаточных количествах поступать в кровь.
Если нарушается процесс связывания железа трансферрином, оно не может эффективно транспортироваться по организму. Поэтому оно не поступает в нужных количествах в клетки красного мозга.
В любом из этих случаев следствием становится снижение способности образования гемоглобина и других железосодержащих белков, т. е. развитие железодефицитной анемии и других обменных нарушений. В результате снижения продукции гемоглобина образующиеся молодые эритроциты имеют меньшие размеры, а их общее количество уменьшается.
Какие анализы необходимо сдать для оценки работы печени
Для проверки состояния печени и выявления возможных проблем медики обычно рекомендуют ряд анализов , которые оценивают биохимические показатели крови и другие параметры. Вот некоторые из основных анализов , которые могут потребоваться для проверки состояния печени : Врач может определить, какие анализы нужно сдать, исходя из медицинской истории пациента, симптомов и предполагаемой проблемы с печенью . Регулярное мониторирование биохимических показателей крови может помочь вовремя выявить изменения в функции печени и приступить к лечению, если это необходимо.
Какие факторы могут повлиять на функциональное состояние почек
Согласно статистике в 70% случаев серьёзные заболевания почек имеют врождённый или генетический характер. В оставшихся 30% к болезням почек приводят различные внешние и внутренние причины. Врождённые патологии вызваны нарушением развития эмбриона на ранних стадиях (до 6 недели), когда идёт закладка внутренних органов. Под влиянием негативных факторов (приём лекарственных препаратов, ионизирующее облучение, токсическое отравление) нервная трубка развивается неправильно, в результате чего почки формируются с нарушениями функциональности. Врождённые патологии разделяются на 4 группы:
Анатомические аномалии
Они встречаются в разной форме у 2,5% младенцев. Чаще всего встречается агенезия (отсутствие одной или обеих почек) или аплазия (недоразвитость органа с полной потерей выполнения своих функций). Агенезия чаще выявляется у младенцев женского пола, в основном страдает правая почка.
Гораздо хуже, если отсутствует левосторонний орган, который более функционален, чем правый и больше приспособлен к компенсаторной функции. Также в 7-11% случаев диагностируется удвоение почки — полное или частичное разделение органа, которое никак не сказывается на функционирование органа, однако имеет свойство провоцировать другие заболевания мочеполовой сферы.
Изменение структуры тканей
В основном наблюдаются изменения чашечно-лоханочной системы, паренхимы, синусов, а также тела почки. Данные патологии редко выявляются сразу после рождения, потому что у новорождённого некоторое время увеличены почечные лоханки, которые выводят продукты метаболизма, накопленные в период внутриутробного развития. В основном изменения структуры тканей почки выявляются во время ультразвукового осмотра.
Почечная недостаточность
Это крайне опасное врождённое заболевание, при котором происходит гибель нефронов — структурных единиц почки, через которые осуществляется фильтрация. На месте погибших нефронов образуется происходит отмирание паренхимы — своеобразной губки, фильтрующей жидкость. В итоге почка отмирает и теряет способность выводить токсины.
У детей, как и у взрослых, острая почечная недостаточность приводит к резкому ухудшению самочувствия. Через некоторое время ребёнок впадает в уремическую кому. При отсутствии экстренной помощи наступает гибель организма. У взрослых недостаточность органа возникает на фоне поликистоза, острого гломерулонефрита (патологической активизации иммунной системы при попадании в почку инфекции), тромбоза артерии.
Патологические изменения, вызванные генетическими мутациями
Наследственная нефропатия — это заболевание почки, вызванное мутацией гена, которое является причиной 9% врождённых заболеваний органа. Так, при синдроме Альпорта поражается ген, отвечающий за строение коллагена мембраны почечных канальцев, внутреннего уха и глаза
В основном мутация встречается у мальчиков. Болезнь приводит к потере функциональности почек, органов зрения и слуха. Хромосомные нарушения сопровождаются множественными пороками развития.
Чаще всего патологии почек возникают при трисомии хромосомы 21, частичной утраты звена 18 хромосомы и др. К врождённым аномалиям органа относят подковообразную форму, смещение, гипоплазию или увеличение мочеточника, как и мультикистоз.
Какими путями железо поступает в организм человека

Железо – важный микроэлемент в организме человека. Самое главное – этот микроэлемент необходим для снабжения тканей, органов и систем человека кислородом, он лежит в основе комфортной жизнедеятельности и функционирования различных процессов организма.
- участвует в образовании гемоглобина, формирует запасы кислорода в крови и принимает участие в его транспортировке к органам
 - поддерживает работу щитовидной железы
 - повышает устойчивость организма к болезнетворным бактериям, формирует иммунитет
 - участвует в обменных процессах
 - защищает организм от действия токсических веществ
 
Норма содержания железа в крови, может отличаться и зависит от различных факторов, в том числе от пола, возраста, роста и веса.
Суточная норма железа:
- для женщин составляет 15–20 мг
 - для мужчин — 8–10 мг
 
Причины дефицита железа: недостаточное поступление в организм и увеличившаяся потребность.
В первом случае речь идет о неправильном питании, во втором дефицит может быть вызван:
- активным ростом у детей
 - беременностью (потребностью плода)
 - нарушением абсорбции (глютеновая болезнь, болезнь Крона, болезни желудка, пожилой возраст)
 - кровопотерями (менструальными или внутренними кишечными)
 - приемом препаратов для лечения заболеваний ЖКТ (антацидов, ингибиторов протонной помпы, H2-блокаторов)
 - интенсивные занятия спортом (повышают потребность в микроэлементах)
 
Дефицит железа в очень редких случаях, возможен при некоторых наследственных заболеваниях.
Потребность в микроэлементе возрастает во время беременности: в некоторых случаях суточная норма может быть увеличена.
Снижение уровня железа в организме — достаточно распространенное явление, что приводит к нарушению синтеза гемоглобина - железосодержащего белка эритроцитов крови и как следствие развивающееся кислородное голодание - страдают сердце, головной мозг, почки.
Симптомы дефицита железа:
- быстрое утомление, человек мёрзнет
 - при нагрузках испытывает одышку
 - кожа бледнеет, шелушится
 - выпадают волосы
 
Специфические симптомы развития железодефицита:
- ногтевые пластины приобретают вогнутую форму
 - пищевые извращения, тяга к несъедобному (мел, известь..)
 - воспаление языка, сопровождающееся жжением и болью
 - воспаление красной каймы губ с трещинами в уголках рта
 
Нарушения глотания и потери сознания, возможны при снижении уровня железа до критических показателей.
У детей из-за нехватки железа замедляется развитие.
Предупредить развитие дефицитных состояний, возможно уделяя должное внимание питанию, включая в рацион соответствующие продукты, при необходимости используя специальные биологически активные добавки.
Лучшие источники железа: красное мясо и субпродукты(печень, сердце), в меньшей степени яйца , бобовые ( чечевица , фасоль ), семена тыквы и кунжута , цельнозерновые крупы ( крупа гречневая ), сухофрукты (яблоки, груши, чернослив), а также некоторые виды зелени — тимьян , петрушка , полевой салат .
Железо в питании подразделяют на гемовое (из мяса и других животных источников) и негемовое (из растительной пищи).
Гемовое железо усваивается наиболее эффективно, на усвоение негемового железа влияют многочисленные факторы .
Усвоение железа улучшает потребляемая вместе с пищей аскорбиновая кислота .
Препятствуют усвоению железа – фитиновая кислота, оксалаты, танины и кофеин.
Избыточное накопление железа в организме оказывает токсическое действие. Передозировка железа стимулирует выработку свободных радикалов , угнетает антиоксидантную систему организма и есть вероятность, что способствует развитию атеросклероза , поэтому употреблять препараты железа здоровым людям не рекомендуется.
Важно!
Помните, приём препаратов и других биологически активных добавок для восполнения дефицита железа, необходимо только после сдачи анализов и консультации врача!
Какие симптомы могут указывать на проблемы с печенью
В случае с заболеваниями этого органа как у женщин, так и у мужчин важно внимательно относиться к минимальным изменениям нормального, здорового состояния и «бить тревогу», если замечаете даже небольшие отклонения от нормы.
Признак №1. Вы чувствуете боль и дискомфорт в правом подреберье, а также в области между лопаток или непосредственно в правой лопатке.
Оценка характера и интенсивности боли может помочь определить наличие патологии. Например, ноющая боль, дискомфорт и ощущение тяжести могут указывать на воспалительный процесс, вызванный токсинами.
Интенсивная и сильная боль в подреберье чаще всего свидетельствует о тяжелом воспалении, включая гнойные процессы, камни в желчных протоках, а также травмы. При передвижении камней в желчевыводящих протоках возникают мучительные ощущения, которые могут быть сопровождаемы резкой болью.
Признак №2. Появление желтого налета на языке и появление горечи в ротовой полости.
Если вы заметили легкую «желтушность» на кончике языка, это может свидетельствовать о ранней стадии гепатита. Однако, если появился желто-зеленый налет, это уже может указывать на серьезные патологии в органах ЖКТ. Застой желчи может проявляться в виде насыщенного желтого налета.
Кроме появления неприятной горечи во рту, также могут возникнуть привкус сладости или «рыбного» запаха, сопровождающиеся запорами, поносом, вздутием живота и рвотой. Эти симптомы могут указывать на проблемы с пищеварительной системой, вызванные проблемами в печени, такими как вирусный гепатит, опухоль или цирроз, а также болезнями ЖКТ или желчного пузыря.
Признак №3. Изменение цвета мочи и кала.
При гепатите или циррозе повышенный уровень билирубина в крови приводит к темному оттенку мочи. При взбалтывании в моче появляется насыщенная желтая пена.
Другие болезни могут приводить к обесцвечиванию кала, повышенной температуре и неприятным ощущениям в правом подреберье, а также к рвотным позывам.
Признак №4. Появление гормонального дисбаланса.
Эти симптомы могут свидетельствовать о проблемах с печенью у мужчин: атрофия яичек, увеличение грудных желез и выпадение волос на лобке и в подмышечных впадинах, вызванные избытком женских гормонов.
Аналогичные проблемы у женщин проявляются в виде таких последствий: увеличивается объем эстрогенов, что может приводить к сыпи по всему телу, усилению неприятных ощущений предменструального синдрома (ПМС) и нарушению менструального цикла.
Признак №5. Постоянное ощущение тошноты и рвота.
Если печень находится под угрозой, то эти симптомы могут проявляться более ярко и длительно.
Например, тошнота может приводить к сильной дегидратации, вызывать ощущение слабости и утомляемости. При длительном течении болезни аппетит может полностью отсутствовать, и вы постепенно начинает терять вес. При этом может возникнуть сильное отвращение к пище и к запахам.
Источник: https://moezdorovieclub.ru/novosti/chto-govorit-vasha-pechen-kak-raspoznat-simptomy-zabolevaniya
 Печень человека расположена в верхней правой части брюшной полости